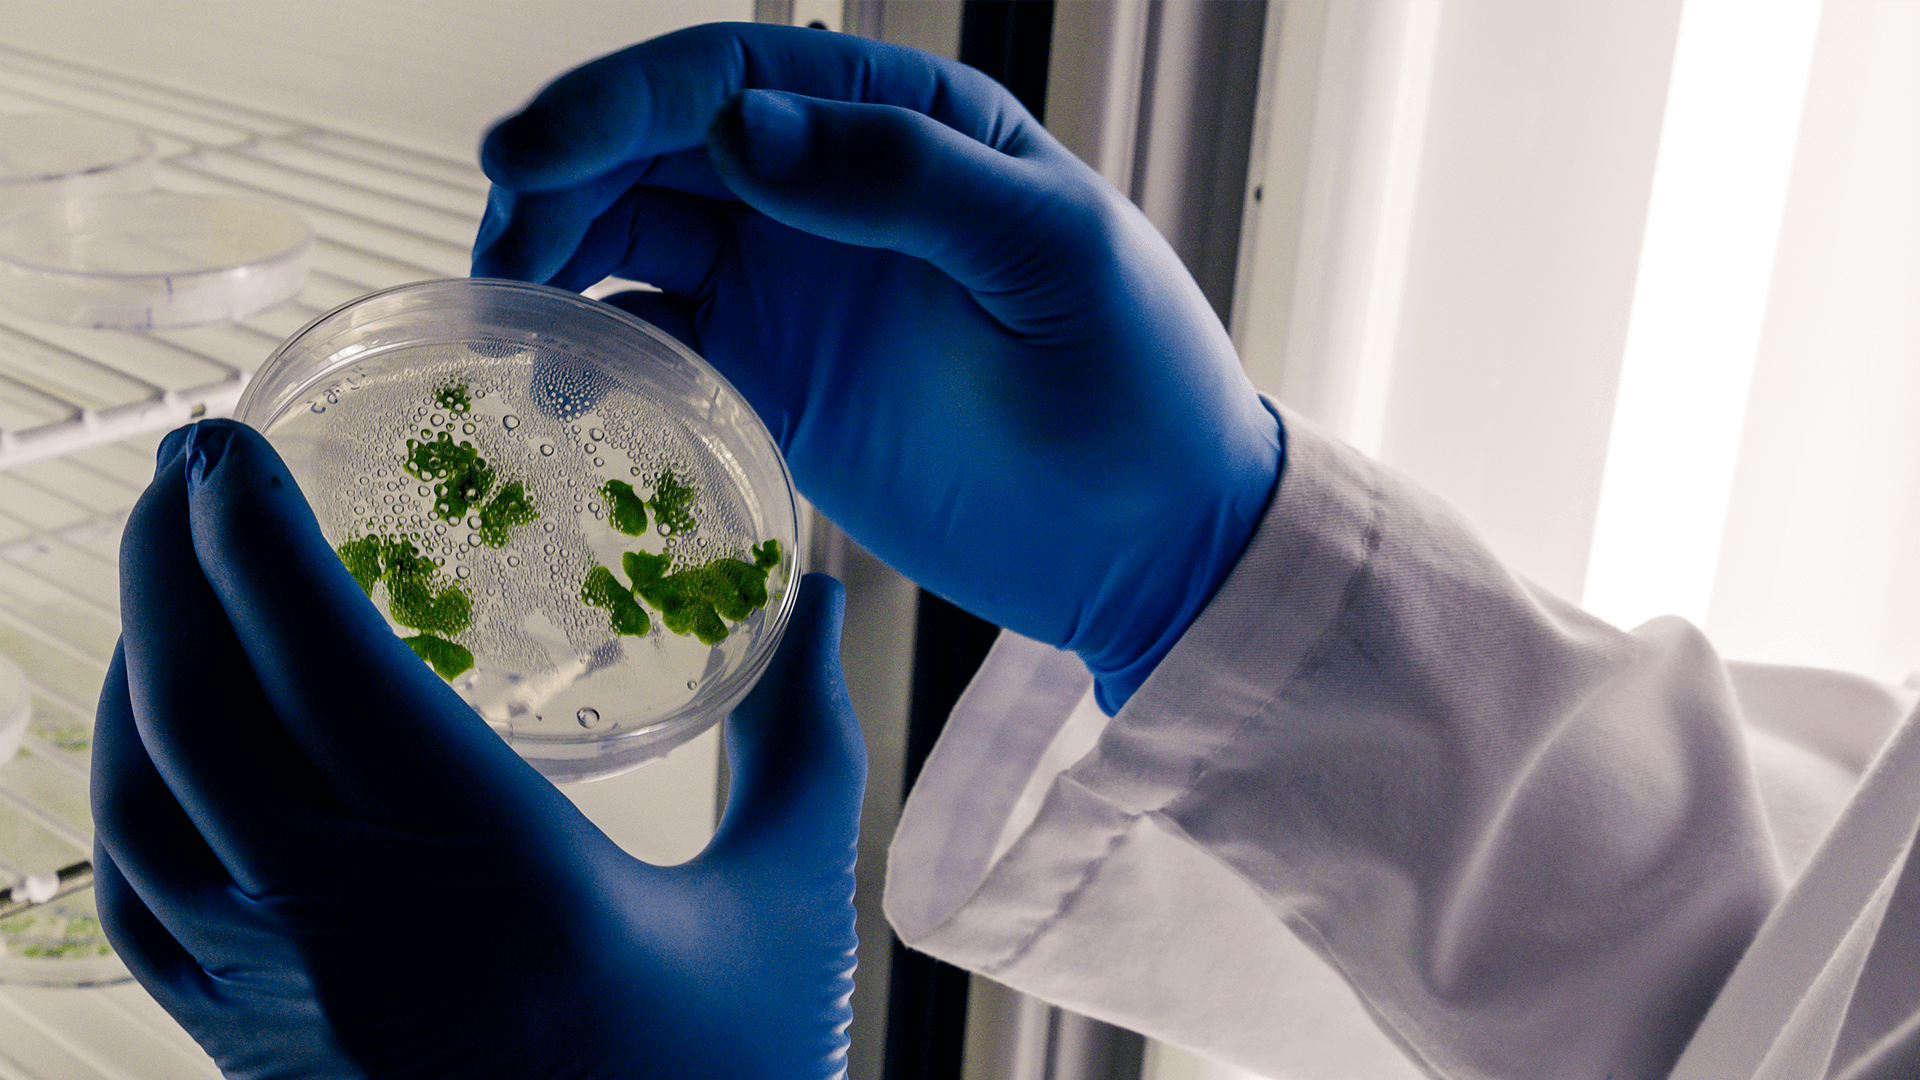

The World Health Organization (WHO) has identified antibiotic resistance as one of the greatest threats to global healthcare systems, as treatments against numerous infections and illnesses are becoming less effective. Fortunately, however, a growing body of scientific research suggests that several cannabinoids have potent anti-bacterial properties, and could provide the solution to antibiotic resistance.
How Cannabis Can Help
Antibiotics are medications that are designed to kill bacteria in order to prevent illnesses and infections. However, their over-use has led to something of a biological arms race between these drugs and the germs they are supposed to destroy, many of which have now evolved to become antibiotic resistant. To rectify this, researchers are interested in developing “helper compounds” which can be added to antibiotics in order to boost their bacteria-killing power.
A study published earlier this year found that cannabidiol (CBD) is likely to be one of the most effective helper compounds out there, as it significantly enhances the efficacy of certain antibiotics[i]. When combined with (CBD), these drugs were found to be much more effective against a type of bacteria called Staphylococcus aureus, which often causes pneumonia, sepsis and other serious illnesses in humans, and which has become resistant to many antibiotics.
The study authors discovered that CBD helps to kill this pathogen by altering its genes so that it can no longer divide and multiply, while also destabilising the bacterial membrane.
Does It Work For All Bacteria?
Bacteria are classified into two broad categories, known as gram-positive and gram-negative bacteria, according to the type of cell wall they possess. As long ago as 1976, researchers discovered that both tetrahydrocannabinol (THC) and CBD are effective at killing gram-positive bacteria, including S. aureus and many other related germs[ii]. Further studies found that cannabis extracts are highly antimicrobial against some of the most common gram-positive pathogens, with all S. aureus within a 14 mm radius of a particular cannabis extract being completely annihilated[iii].
Exactly which cannabinoids are responsible for this antibacterial effect is something that is still being investigated, although research indicates that cannabigerol (CBG) may play a crucial role. In one recent study, CBG was found to be more effective than both CBD and THC at destroying antibiotic resistant germs like MRSA, as it prevents these microbes from grouping together into colonies called biofilms[iv].
Interestingly, CBG was also found to be effective against gram-negative bacteria, with the researchers noting that it appears to destabilise the inner membrane of germs in this category.
A separate study found that CBD is also a potent destroyer of gram-negative bacteria such as E. coli, but works via a different mechanism. The study authors discovered that just one treatment with CBD inhibits the ability of E. coli to form membrane vesicles, which are tiny bundles of proteins that are released by all gram-negative bacteria, and which play a crucial role in cell communication, pathogen-host interactions and antibiotic resistance[v].
So Is Smoking Weed Better Than Taking Antibiotics?
Despite the antibacterial punch that several cannabinoids carry, there is still some uncertainty over how to harness this benefit. Early studies indicated that both THC and CBD become much less effective when they are dissolved in blood, which means that smoking marijuana is unlikely to be a viable treatment for bacterial infections.
To date, most of the research into the antibiotic properties of cannabis has been carried out in petri dishes, and we still can’t say with any certainty how effective cannabinoids are at fighting off pathogens inside the body.
However, as evidence for the bactericidal properties of marijuana continues to grow, it seems increasingly likely that the solution to antibiotic resistance will come from cannabis.
[i] Wassmann CS, Højrup P, Klitgaard JK. Cannabidiol is an effective helper compound in combination with bacitracin to kill Gram-positive bacteria. Scientific reports. 2020 Mar 5;10(1):1-2. - https://www.nature.com/articles/s41598-020-60952-0
[ii] Van Klingeren B, Ten Ham M. Antibacterial activity of Δ 9-tetrahydrocannabinol and cannabidiol. Antonie van Leeuwenhoek. 1976 Mar 1;42(1-2):9-12. - https://link.springer.com/article/10.1007/BF00399444
[iii] Sarmadyan H, Solhi H, Najarian-Araghi N, Ghaznavi-Rad E. Determination of the Antimicrobial Effects of Hydro-Alcoholic Extract of Cannabis Sativa on Multiple Drug Resistant Bacteria Isolated from Nosocomial Infections. Iranian Journal of Toxicology. 2014 Jan 10;7(23):967-72. - http://ijt.arakmu.ac.ir/article-1-269-en.pdf
[iv] Farha MA, El-Halfawy OM, Gale RT, MacNair CR, Carfrae LA, Zhang X, Jentsch NG, Magolan J, Brown ED. Uncovering the hidden antibiotic potential of Cannabis. ACS Infectious Diseases. 2020 Feb 4;6(3):338-46. - https://pubs.acs.org/doi/10.1021/acsinfecdis.9b00419
[v] Kosgodage US, Matewele P, Awamaria B, Kraev I, Warde P, Mastroianni G, Nunn AV, Guy GW, Bell JD, Inal JM, Lange S. Cannabidiol is a novel modulator of bacterial membrane vesicles. Frontiers in Cellular and Infection Microbiology. 2019 Sep 10;9:324. - https://www.frontiersin.org/articles/10.3389/fcimb.2019.00324/full?fbclid=IwAR2FIlLv_zAW0SmTKSdRUtwFdK_0wBfqnorPH75wXL_OcWG144lefkXTVno